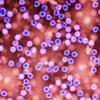

Zaradi povečanega števila bolnikov z okužbami dihal in zaradi boljšega nadzora nad epidemiološko situacijo, z današnjim dnem omejujejo obiske tudi na ljubljanski pediatrični kliniki in na oddelku za otroško kirurgijo in intenzivno terapijo Kirurške klinike.
Dovoljen je obisk ene zdrave odrasle osebe, ki je ves čas ob hospitaliziranem otroku, ter ene zdrave odrasle osebe, ki pripelje otroka na ambulantni pregled ali sprejem na kliniko: "Pri obiskih v Enoti za intenzivno terapijo otrok si pridržujemo pravico, da režim, v dogovoru z lečečim zdravnikom, prilagajamo vsakemu bolniku posebej," so še sporočili iz UKC Ljubjana.
Obiske so v minulih dneh omejili tudi v nekaterih drugih bolnišnicah.